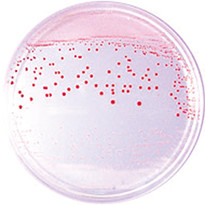
コロニー検査
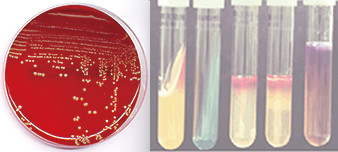
色調判断

例:インキュベーター(温度を一定に保つ機能を有する装置)が故障した
- 反応を止める方法は無いのだろうか?
最低限何ができるだろうか? - 故障の影響が、土日や週末を挟んで困っている。
最低限の応急対策は?
御社製品の安全性などの“ 検査で重要な役割” を担われている食品検査室
こんな“ 不安” や“ お困りごと” はありませんか?
エフエスエー(FSA)では、食品検査に対する30 年以上の実績と大手試薬・培地メーカーとの協力により、
検査室を総合支援致します。
※過去に頂いたお問合せ・ご相談の例

例:インキュベーター(温度を一定に保つ機能を有する装置)が故障した
JFS-B規格
JFS-G規格| 番号 | 項目 | 要求事項 |
|---|---|---|
| GMP7 | 教育・訓練 |
⇒検査に関連するOJT等 |
| FSM19 | 検査 |
⇒検査に関連するOJT等 |
| 番号 | 項目 | 要求事項 |
|---|---|---|
| GMP-G 18 | 教育・訓練 | 食品取扱者全員がそれぞれの業務に応じて、食品安全の確保及び実務に関する十分な教育・訓練を受けるよう、責任及び権限に応じた教育訓練プログラム(内容、実施時期、方法、頻度等)を定め、その実施は記録しなければならない。 |